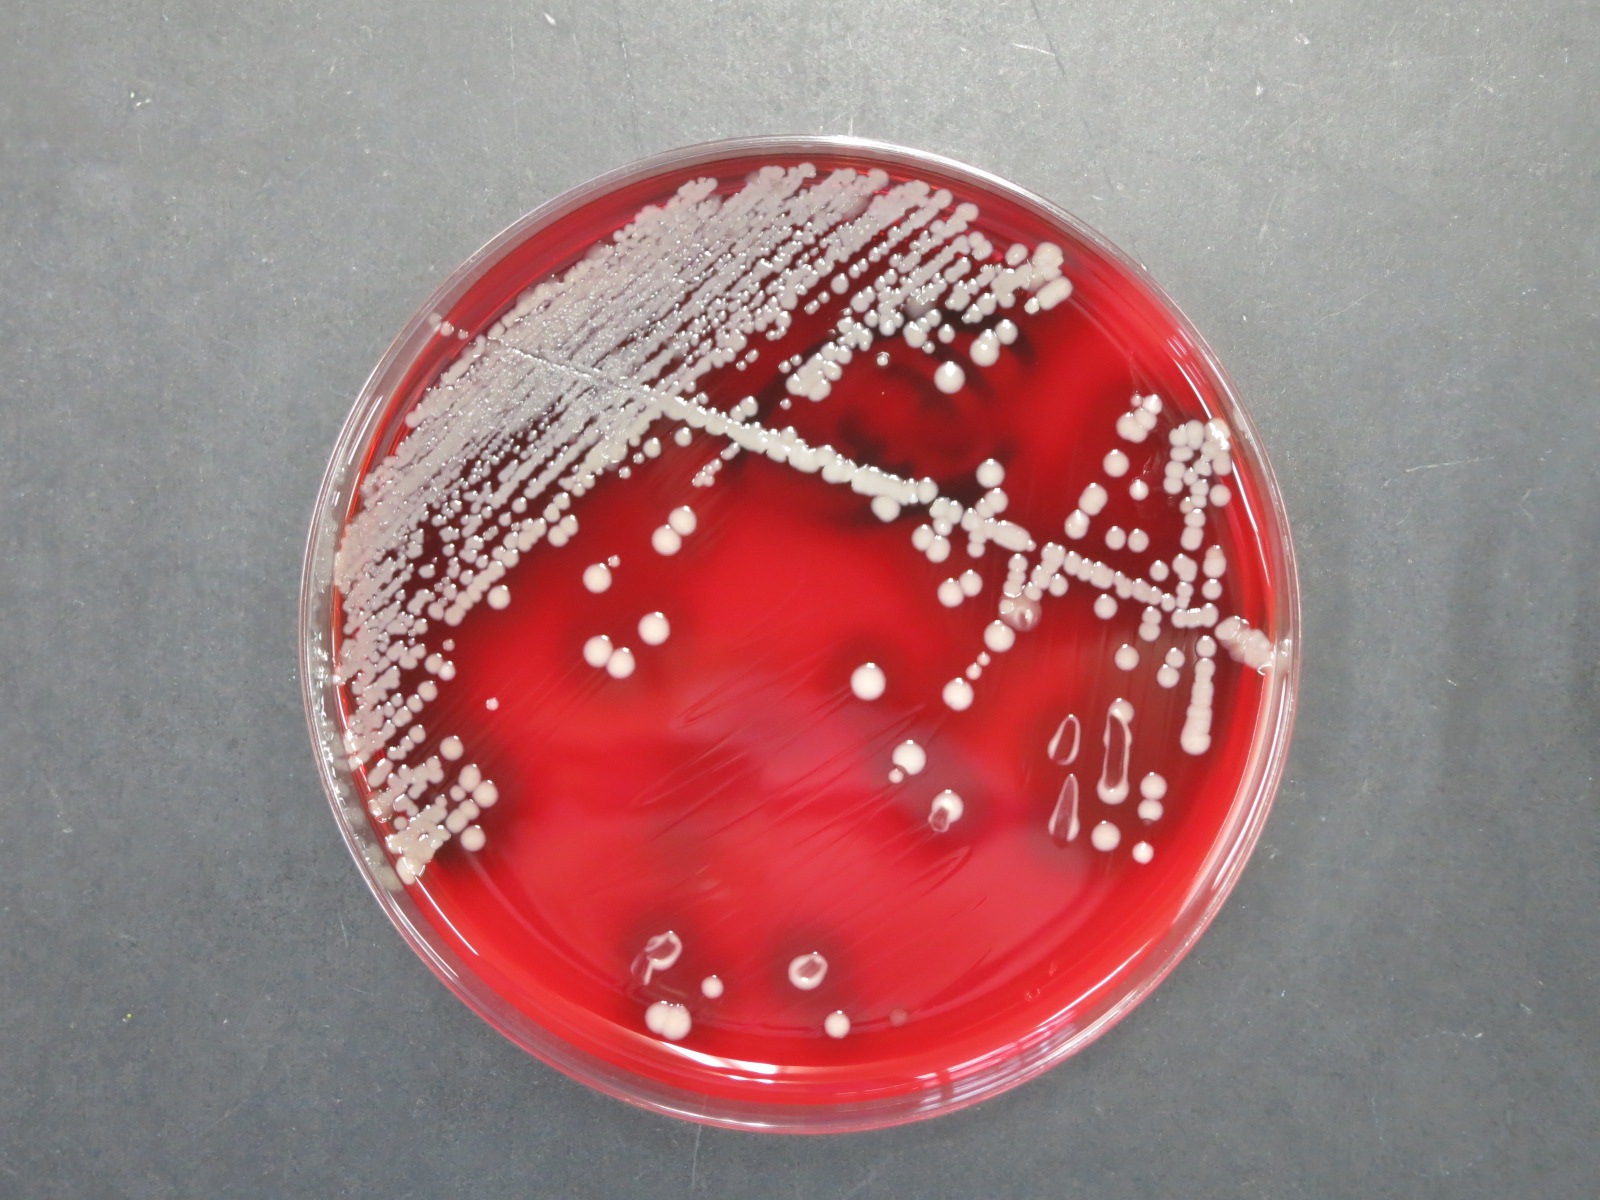

紹介します 平成27年11月
登録日:2016年2月18日
紹介します 平成27年11月分記事一覧
当院公式フェイスブックで平成27年11月に掲載した当院を紹介する記事です。
【整形外科の相澤利武先生がラジオ番組に出演します!】平成27年11月6日
明日11月7日(土)に、当院の診療局長で、整形外科の相澤利武先生がラジオ番組に出演します!
ラジオ福島 特別番組「関節痛治療最前線!」
放送日時:11月7日(土)午後6時45分~
最新の関節痛治療について相澤先生がお話します。ぜひ、お聴きください!

【楽秋膳(らくしゅうぜん)を提供しました】平成27年11月9日
10月21日の夕食に、楽秋膳を(らくしゅうぜん)を提供しました。
楽秋膳は秋の味覚を集めた行事食として、毎年実施しています。今年は、栗、しめじ、しいたけ、ごぼう、にんじんを炊きこんだ秋の実ごはん、秋刀魚の塩焼き、さつま芋と切り昆布の甘煮、おろしあえ、みそ汁の献立でした。
今回は、静かな秋の一夜、季節の味が味覚と視覚、そして心にほっとやすらぎを感じていただけるよう考えました。
行事食は、入院中でも季節を感じていただけるように、心をこめて提供しています。今後も、行事食の紹介をしていきますので、お楽しみに!

【福島県臨床検査技師会学術奨励賞を受賞しました】平成27年11月11日
中央検査室の松本康歳技師が、平成27年度福島県臨床検査技師会学術奨励賞を受賞しました。学術奨励賞は技師会関係の学会発表,学会活動等を受賞基準として選考されます。
この度の受賞は,松本技師の福島医学検査学会での支部学術活動および座長経験や日本臨床衛生検査技師会北日本支部学会での「当院で経験した肺外結核の一症例」を始めとする学会発表,機関紙「臨床病理」への論文「血液透析患者における鉄の評価と採血時間の違いによる変動について」の投稿などが認められたものです。
松本技師は,現在細菌検査室に勤務しており、喀痰や便などの検体から、肺炎や食中毒などの感染症の原因となる微生物の検査をしています。
松本技師に授賞の感想を聞いたところ「今回の受賞を励みに、今後も継続して一層の研鑚を積みたい。」と意気込みを語ってくれました!
今後も、当院で活躍する技師の紹介をしていきます!
(左・中:松本技師 右:敗血症の患者さんからみられた黄色ブドウ球菌)
このページに関するお問い合わせ先
医療センター 経営企画課
電話番号: 0246-26-2134 ファクス: 0246-26-2404